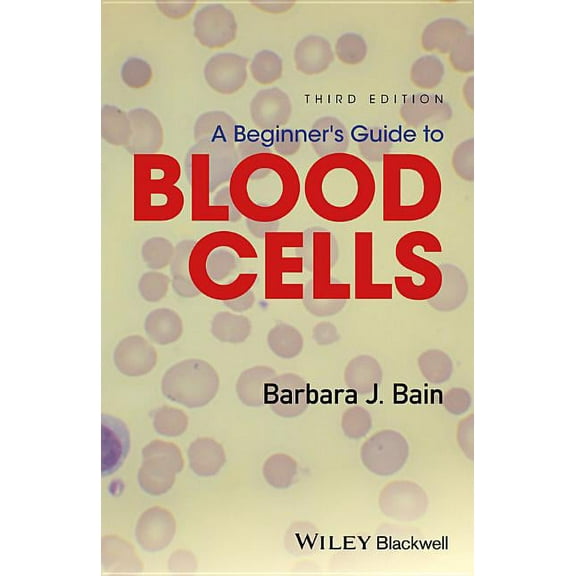
A Beginner's Guide to Blood Cells, (Paperback)

Sort by|
Selected filters
Barbara J Bain Hematology Books in Medical Books(9)
Uses item details. Price when purchased online
A Beginner's Guide to Blood Cells, (Paperback) $41.88
$4188
current price $41.88A Beginner's Guide to Blood Cells, (Paperback)
Save with
Free shipping, arrives in 3+ days
A - Z of Haematology, (Paperback) $53.94

$5394
current price $53.94A - Z of Haematology, (Paperback)
Save with
Free shipping, arrives in 3+ days
Blood Cells: A Practical Guide (Hardcover) $225.44

$22544
current price $225.44Blood Cells: A Practical Guide (Hardcover)
Free shipping, arrives in 3+ days
Multiple Choice Questions for Haematology and Core Medical Trainees, (Paperback) $41.02

$4102
current price $41.02Multiple Choice Questions for Haematology and Core Medical Trainees, (Paperback)
Save with
Free shipping, arrives in 3+ days
Dacie and Lewis Practical Haematology, (Paperback) $117.92

$11792
current price $117.92Dacie and Lewis Practical Haematology, (Paperback)
Free shipping, arrives in 3+ days
Hematology: 101 Morphology Updates, (Paperback) $75.80

$7580
current price $75.80Hematology: 101 Morphology Updates, (Paperback)
Free shipping, arrives in 3+ days
Haemoglobinopathy Diagnosis, (Hardcover) $148.57

$14857
current price $148.57Haemoglobinopathy Diagnosis, (Hardcover)
Free shipping, arrives in 3+ days
Bone Marrow Pathology, (Hardcover) $189.64

$18964
current price $189.64Bone Marrow Pathology, (Hardcover)
Free shipping, arrives in 3+ days
Pre-Owned Haemoglobinopathy Diagnosis (Hardcover) $27.99 Was $61.49

Now$2799
current price Now $27.99, Was $61.49$61.49
Pre-Owned Haemoglobinopathy Diagnosis (Hardcover)
Free shipping, arrives in 3+ days
Pre-Owned: Good